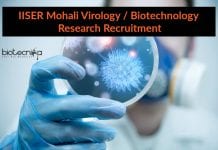
IISER Mohali Virology / Biotechnology Research Recruitment IISER Mohali Virology

CCMB Scientists Develop New Low-Cost COVID-19 Test
New Low-Cost Coronavirus Test Developed By CCMB Scientists
Reverse transcription-polymerase chain reaction (RT-qPCR) test is the only recommended test for COVID-19 by the Indian Council...
Govt Silk Board Job Recruitment – Project Assistant Vacancy Available
Govt Silk Board Job Recruitment - Project Assistant Vacancy Available
Govt Silk Board Job Recruitment - Project Assistant Vacancy Available. MSc Zoology Project Assistant opportunities...
IISER TVM Epigenetic Modulation Project Jobs – Biological Sciences Apply
IISER TVM Biological Science Vacancy - Epigenetic Modulation Project Jobs
IISER TVM Biological Science Vacancy - Epigenetic Modulation Project Jobs. IISER TVM is hiring MSc...
What Salary Should You Expect After MSc Biotechnology?
Salary For MSc Biotechnology - What Should You Expect?
The million-dollar question, quite literally on all of our minds! Ever since time immemorial, the constant...
ICAR-NBPGR Online Interview for Project Associate Job Opening
ICAR-NBPGR Project Associate Job Opening - Online Interview
ICAR-NBPGR Project Associate Job Opening - Online Interview. MSc Botany/ Molecular Biology/ Life Science Jobs. MSc candidates...
Rare Heart Bone In Chimpanzees Discovered
Scientists Discover Rare heart bone in chimpanzees
A rare heart bone was discovered in some chimpanzees by the scientists of the University of Nottingham. The...
China Removes Pangolin From Traditional Medicine List
Endangered pangolin removed from traditional medicines in china
Pangolin parts have been removed from the official list of traditional medicines by China, days after increasing...
Coronavirus Transmission: How Quickly Can Coronavirus Spread On Hospital Surface?
Coronavirus Transmission: How quickly can coronavirus spread via hospital surface?
New research by College University London and Great Ormond Street Hospital (GOSH) has aimed to...
Cancer Immunotherapy Tools To Identify COVID-19 Vaccine Targets
COVID-19 Vaccine Targets Using Immunotherapy Tools
Using cancer immunotherapy tools, researchers identify targets for a COVID-19 vaccine.
The strategy of using the tools used for the...
$100 Million Investment On Potential COVID-19 Vaccine By Serum Institute of India
Serum Institute $100 Million Investment On
Potential COVID-19 Vaccine
According to a company official at the Serum Institute of India, the institute is investing $100 million...
IISER Mohali Virology / Biotechnology Research Recruitment
IISER Mohali Virology / Biotechnology Research Recruitment
IISER Mohali Virology / Biotechnology Research Recruitment. Junior Research Fellow vacancies for MSc Biotech/Mol Bio/ Virology/ Immunology candidates....
Govt Ministry of AYUSH CARIDD Research Fellow Recruitment
Govt Ministry of AYUSH CARIDD Research Fellow Recruitment
Govt Ministry of AYUSH CARIDD Research Fellow Recruitment. CARIDD is recruiting msc botany candidates. MSc Botany jobs...
Govt Food Technologist Jobs With Rs. 1.45 Lakhs pm Salary
Govt Food Technologist Jobs With Rs. 1.45 Lakhs pm Salary
Govt Food Technologist Jobs With Rs. 1.45 Lakhs pm Salary. MSc/ BTech Food Technology Job...
Biotecnika Times – Newsletter 11.06.2020 – Govt COVID RT-PCR MSc Job, IIT-AIIMS Joint
Biotecnika Times - Govt COVID RT-PCR MSc Job, IIT-AIIMS Joint
Govt COVID-19 RT-PCR Lab MSc Life Science Recruitment
Govt Health & Family Welfare COVID-19 RT-PCR Lab...
DRDO Funded Project Recruitment for Life Sciences at BITS Pilani
BITS Pilani Project Recruitment for Life Sciences in DRDO Project
BITS Pilani Project Recruitment for Life Sciences in DRDO Project. MSc Life Sciences/ Biotechnology/ Biochemistry/...